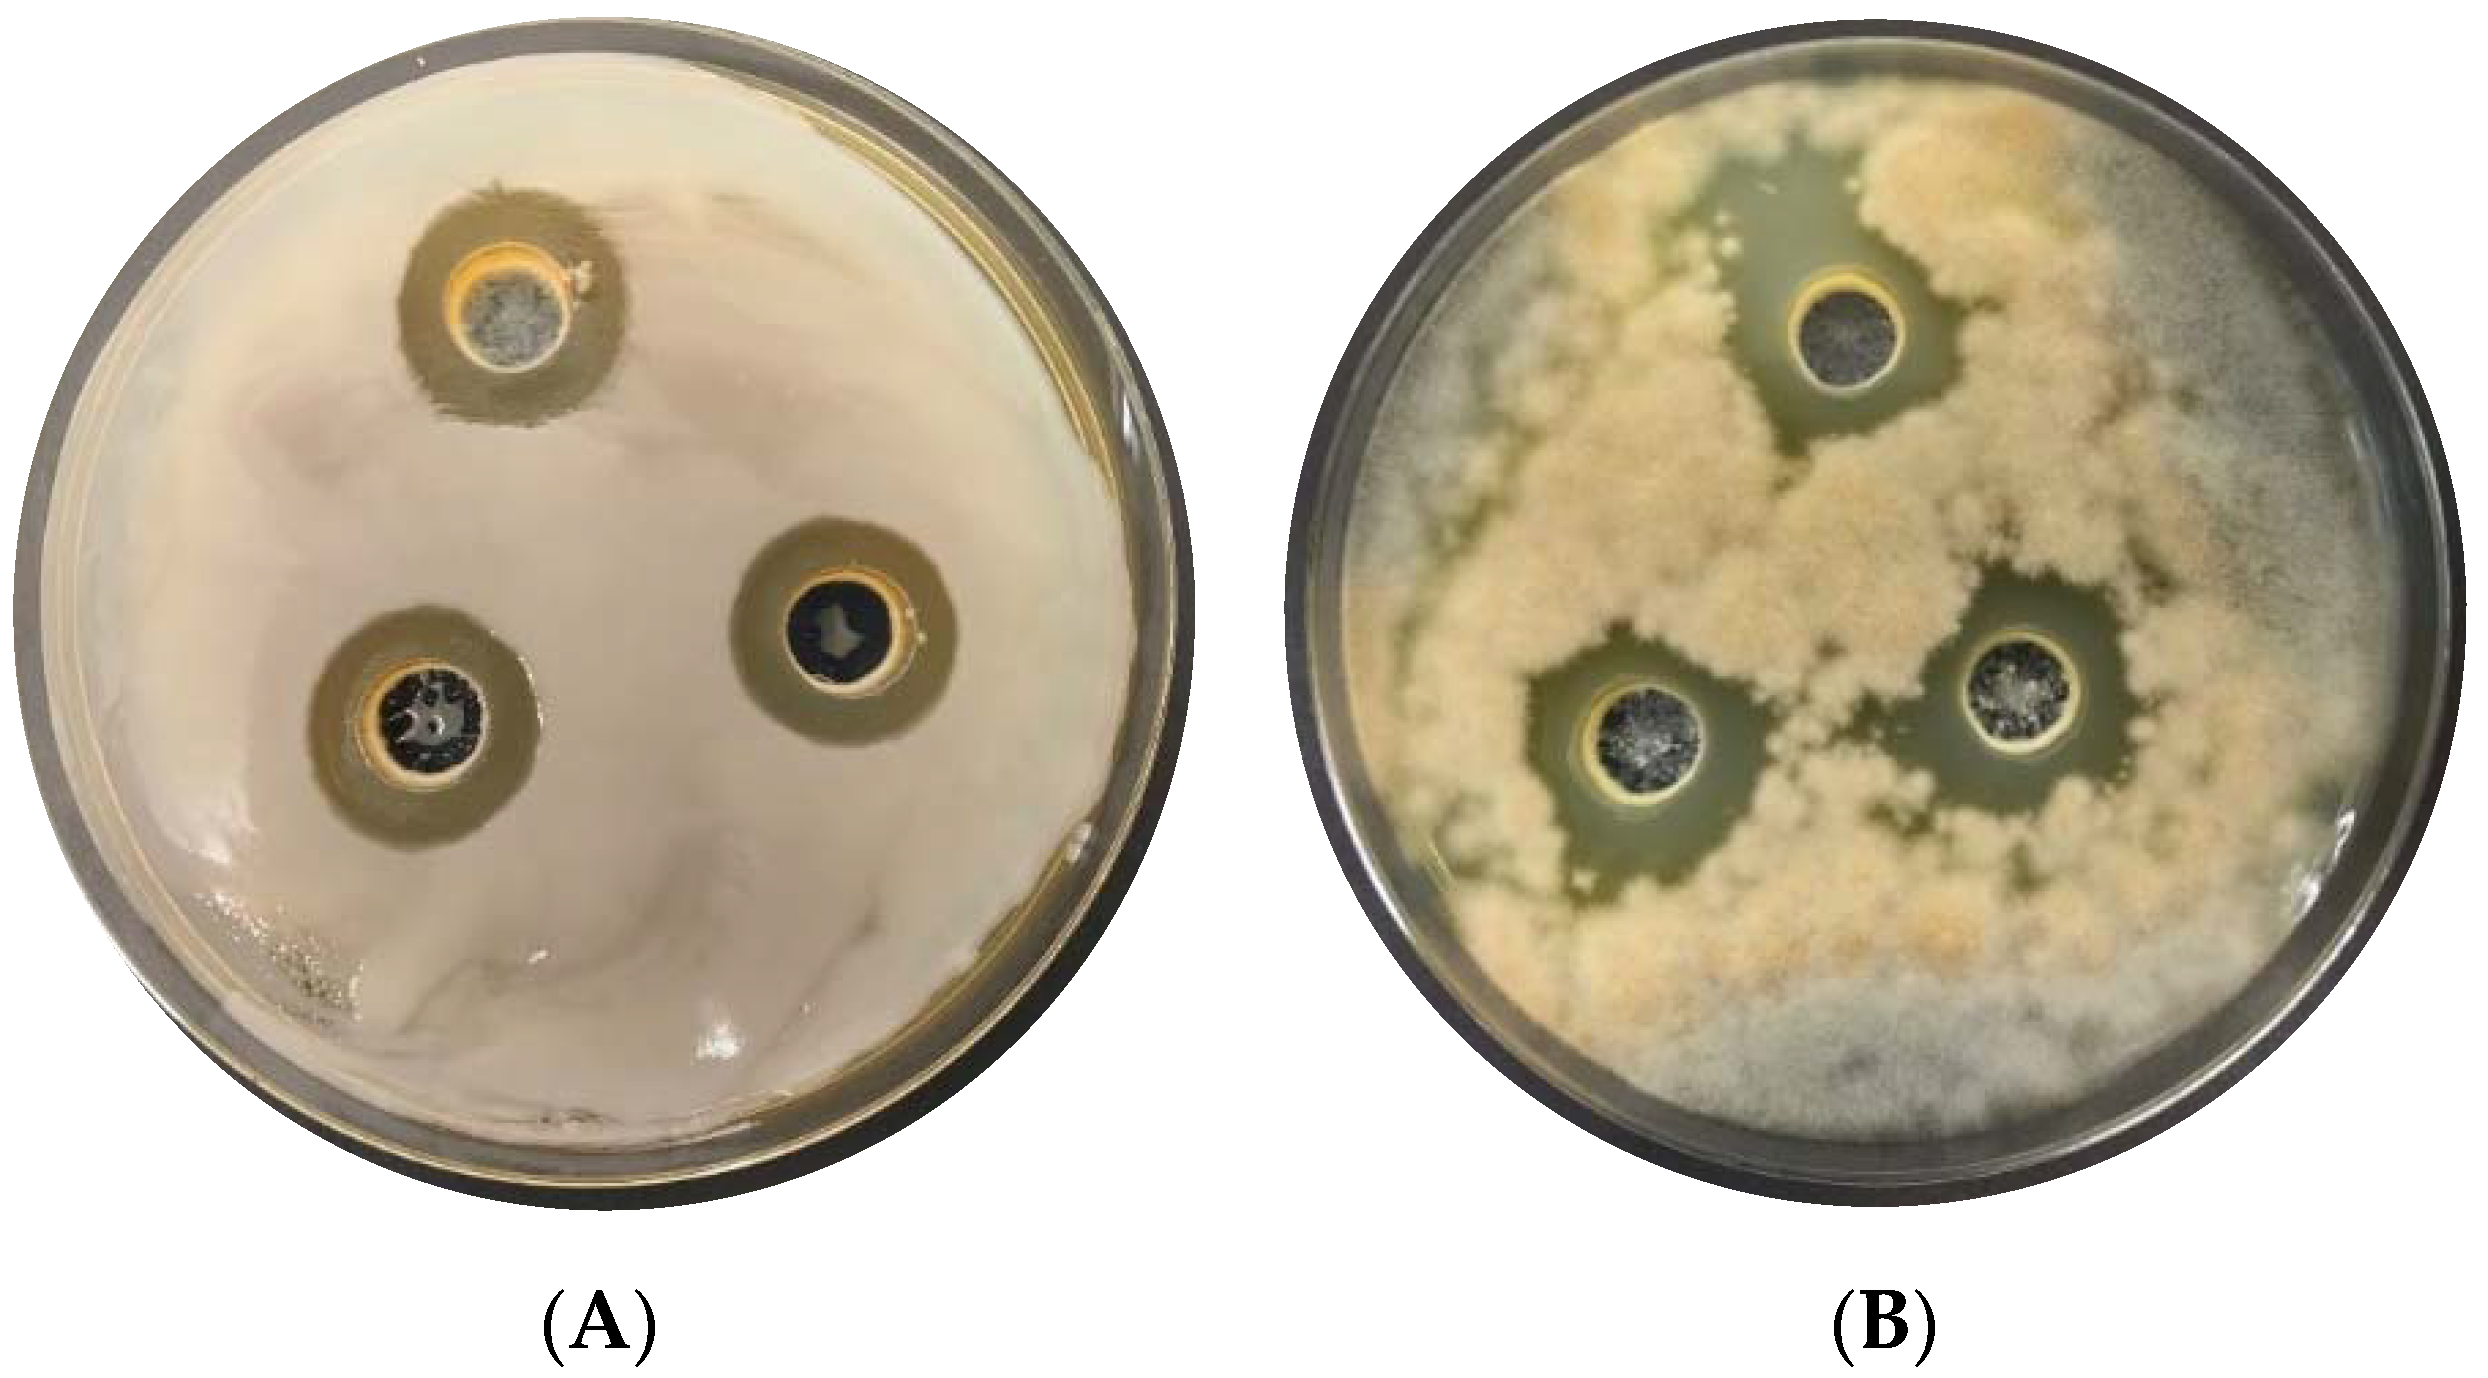

Lactic Acid Bacteria as Biocontrol Agents against Potato (Solanum tuberosum L.) Pathogens
Abstract
:Featured Application
Abstract
1. Introduction
2. Materials and Methods
2.1. Microorganisms Used in the Research
2.1.1. Lactic Acid Bacteria (LAB)
2.1.2. Potato Phytopathogens
2.2. Agar-Plug Diffusion Method for In Vitro Antimicrobial Assay
2.3. High-Performance Liquid Chromatography (HPLC) for Lactic Acid Bacteria Fermentation by-Products Determination
2.4. Optimisation of the Acid Whey-Based Culture Media for Cultivation of L. plantarum KB2 LAB 03
2.4.1. Acid Whey-Based Culture MEDIA
2.5. Agar-Well Diffusion Method for In Vitro Antimicrobial Assay
2.6. Analytical Methods for Culture Media Characteristics
2.7. In Situ Antimicrobial Assay on Seed Potato
2.8. Statistical Analysis
3. Results and Discussion
3.1. Antimicrobial Activity of Lactic Acid Bacteria In Vitro
3.2. Determination of Metabolites Production by Selected Strains of Lactic Acid Bacteria by HPLC
3.3. Growth Medium Selection for L. plantarum KB2 LAB 03 Cultivation
3.4. In Situ Test of Biocontrol Potential of L. plantarum KB2 LAB 03 against Pathogens on Potatoes
4. Conclusions
5. Patents
Supplementary Materials
Author Contributions
Funding
Institutional Review Board Statement
Informed Consent Statement
Data Availability Statement
Acknowledgments
Conflicts of Interest
References
- Camire, M.E.; Kubow, S.; Donnelly, D.J. Potatoes and Human Health. Crit. Rev. Food Sci. Nutr. 2009, 49, 823–840. [Google Scholar] [CrossRef]
- Eurostat. The EU Potato Sector—Statistics on Production, Prices and Trade. 2021. Available online: https://ec.europa.eu/eurostat/statistics-explained/index.php?title=The_EU_potato_sector_-_statistics_on_production,_prices_and_trade (accessed on 30 April 2022).
- Statistics Poland. Wynikowy Szacunek Głównych Ziemiopłodów Rolnych I Ogrodniczych W 2021 R (The Resulting Estimate of the Main Agricultural and Horticultural Crops in 2021). Available online: https://stat.gov.pl/obszary-tematyczne/rolnictwo-lesnictwo/uprawy-rolne-i-ogrodnicze/wynikowy-szacunek-glownych-ziemioplodow-rolnych-i-ogrodniczych-w-2021-roku,5,20.html (accessed on 30 April 2022).
- FAO. Top Countries in Potatoes Production. Potatoes Production—Food and Agriculture Organization of the United Nations; FAO: Rome, Italy, 2019. [Google Scholar]
- Smith, I.M. European Handbook of Plant Diseases; Smith, I.M., Dunez, J., Phillips, D.H., Lelliott, R.A., Archer, S.A., Eds.; Blackwell Scientific Publications: Oxford, UK, 2009. [Google Scholar]
- Olsen, N.; Miller, J.; Nolte, P. Diagnosis & Management of Potato Storage Diseases; University of Idaho, College of Agricultural and Life Sciences: Moscow, Idaho, 2006. [Google Scholar]
- Charkowski, A.; Sharma, K.; Parker, M.L.; Secor, G.A.; Elphinstone, J. The Potato Crop; Springer International Publishing: Berlin, Germany, 2020; pp. 351–388. [Google Scholar]
- Khayi, S.; Cigna, J.; Chong, T.M.; Quêtu-Laurent, A.; Chan, K.-G.; Hélias, V.; Faure, D. Transfer of the potato plant isolates of Pectobacterium wasabiae to Pectobacterium parmentieri sp. nov. Int. J. Syst. Evol. Microbiol. 2016, 66, 5379–5383. [Google Scholar] [CrossRef]
- Han, L.; Dutilleul, P.; Prasher, S.O.; Beaulieu, C.; Smith, D.L. Assessment of Common Scab-Inducing Pathogen Effects on Potato Underground Organs Via Computed Tomography Scanning. Phytopathology 2008, 98, 1118–1125. [Google Scholar] [CrossRef] [Green Version]
- Stammler, G.; Bohme, F.; Philippi, J.; Miessner, S.; Tegge, V. Pathogenicity of Alternaria-species on potatoes and tomatoes. Spec. Rep. Appl. Plant R. 2014, 16, 85–96. [Google Scholar]
- A’Hara, D. Detection and Identification of Phoma Pathogens of Potato. In Plant Pathology; Springer: Berlin/Heidelberg, Germany, 2015; pp. 17–27. [Google Scholar]
- Sukul, P.; Spiteller, M. Metalaxyl: Persistence, degradation, metabolism, and analytical methods. Rev. Environ. Contam. Toxicol. 2000, 164, 1–26. [Google Scholar]
- Huang, Z.; Wang, P.; Pu, Z.; Lu, L.; Chen, G.; Hu, X.; Fayyaz, A.; Gai, Y. Effects of mancozeb on citrus rhizosphere bacterial community. Microb. Pathog. 2021, 154, 104845. [Google Scholar] [CrossRef]
- OuYang, M.-N.; Liu, X.; Guo, H.-M.; Lu, Z.-H.; Zhou, D.-D.; Yang, Z.-H. The different toxic effects of metalaxyl and metalaxyl-M on Tubifex tubifex. Ecotoxicol. Environ. Saf. 2021, 208, 111587. [Google Scholar] [CrossRef]
- Eurostat, 2013: Glossary: Organic Farming. Statistics Explained. Available online: https://ec.europa.eu/eurostat/statistics-explained/index.php?title=Glossary:Organic_farming&oldid=122448 (accessed on 30 April 2022).
- Pal, K.K.; McSpadden Gardener, B. Biological Control of Plant Pathogens. Plant Health Instr. 2006, 1–25. [Google Scholar] [CrossRef] [Green Version]
- Devakumar, N.; Shubha, S.; Rao, G.G.; Gowda, S.B. Multiplication of bio-control agents on locally available organic media. Build. Org. Bridg. 2014, 20, 643–646. [Google Scholar]
- Fiocco, D.; Capozzi, V.; Collins, M.; Gallone, A.; Hols, P.; Guzzo, J.; Weidmann, S.; Rieu, A.; Msadek, T.; Spano, G. Characterization of the CtsR Stress Response Regulon in Lactobacillus plantarum. J. Bacteriol. 2010, 192, 896–900. [Google Scholar] [CrossRef] [Green Version]
- Seddik, H.A.; Bendali, F.; Gancel, F.; Fliss, I.; Spano, G.; Drider, D. Lactobacillus plantarum and Its Probiotic and Food Potentialities. Probiotics Antimicrob. Proteins 2017, 9, 111–122. [Google Scholar] [CrossRef] [PubMed]
- Gerez, C.L.; Torres, M.J.; Font de Valdez, G.; Rollán, G. Control of spoilage fungi by lactic acid bacteria. Biol. Control 2013, 64, 231–237. [Google Scholar] [CrossRef]
- Arena, M.P.; Silvain, A.; Normanno, G.; Grieco, F.; Drider, D.; Spano, G.; Fiocco, D. Use of Lactobacillus plantarum Strains as a Bio-Control Strategy against Food-Borne Pathogenic Microorganisms. Front. Microbiol. 2016, 7, 464. [Google Scholar] [CrossRef] [PubMed] [Green Version]
- Balouiri, M.; Sadiki, M.; Ibnsouda, S.K. Methods for in vitro evaluating antimicrobial activity: A review. J. Pharm. Anal. 2016, 6, 71–79. [Google Scholar] [CrossRef] [PubMed] [Green Version]
- Czyżowska, A.; Kucharska, A.Z.; Nowak, A.; Sokół-Łętowska, A.; Motyl, I.; Piórecki, N. Suitability of the probiotic lactic acid bacteria strains as the starter cultures in unripe cornelian cherry (Cornus mas L.) fermentation. J. Food Sci. Technol. 2017, 54, 2936–2946. [Google Scholar] [CrossRef] [PubMed]
- Rice, E.W.; Baird, R.B.; Eaton, A.D.; Clesceri, L.S. (Eds.) Standard Methods for the Examination of Water and Wastewater; American Public Health Association (APHA), American Water Works Association (AWWA) and Water Environment Federation (WEF): Washington, DC, USA, 2012. [Google Scholar]
- EN ISO 20483:2013; Cereals and Pulses—Determination of the Nitrogen Content and Calculation of the Crude Protein Content—Kjeldahl Method. ISO: Geneva, Switzerland, 2013.
- Steglińska, A.; Bekhter, A.; Wawrzyniak, P.; Kunicka-Styczyńska, A.; Jastrząbek, K.; Fidler, M.; Śmigielski, K.; Gutarowska, B. Antimicrobial Activities of Plant Extracts against Solanum tuberosum L. Phytopathogens. Molecules 2022, 27, 1579. [Google Scholar] [CrossRef]
- Mokoena, M.P.; Omatola, C.A.; Olaniran, A.O. Applications of lactic acid bacteria and their bacteriocins against food spoilage microorganisms and foodborne pathogens. Molecules 2021, 26, 7055. [Google Scholar] [CrossRef]
- Nasrollahzadeh, A.; Mokhtari, S.; Khomeiri, M.; Saris, P.E.J. Antifungal Preservation of Food by Lactic Acid Bacteria. Foods 2022, 11, 395. [Google Scholar] [CrossRef]
- Perczak, A.; Goliński, P.; Bryła, M.; Waśkiewicz, A. The efficiency of lactic acid bacteria against pathogenic fungi and mycotoxins. Arh. Hig. Rada Toksikol. 2018, 69, 32–45. [Google Scholar] [CrossRef] [PubMed] [Green Version]
- Muhialdin, B.J.; Saari, N.; Meor Hussin, A.S. Review on the Biological Detoxification of Mycotoxins Using Lactic Acid Bacteria to Enhance the Sustainability of Foods Supply. Molecules 2020, 25, 2655. [Google Scholar] [CrossRef]
- Liu, Y.; Galani Yamdeu, J.H.; Gong, Y.Y.; Orfila, C. A review of postharvest approaches to reduce fungal and mycotoxin contamination of foods. Compr. Rev. Food Sci. Food Saf. 2020, 19, 1521–1560. [Google Scholar] [CrossRef] [PubMed]
- Li, J.; Wang, W.; Chen, S.; Shao, T.; Tao, X.; Yuan, X. Effect of Lactic Acid Bacteria on the Fermentation Quality and Mycotoxins Concentrations of Corn Silage Infested with Mycotoxigenic Fungi. Toxins 2021, 13, 699. [Google Scholar] [CrossRef] [PubMed]
- Hamed, H.A.; Moustafa, Y.A.; Abdel-Aziz, S.M. In vivo efficacy of lactic acid bacteria in biological control against Fusarium oxysporum for protection of tomato plant. Life Sci. J. 2011, 8, 462–468. [Google Scholar]
- Wang, H.K.; Yan, Y.H.; Wang, J.M.; Zhang, H.P.; Qi, W. Production and characterization of antifungal compounds produced by Lactobacillus plantarum IMAU10014. PLoS ONE 2012, 7, e29452. [Google Scholar] [CrossRef] [Green Version]
- Abdel-Aziz, S.M.; Moustafa, Y.A.; Hamed, H.A. Lactic Acid Bacteria in the Green Biocontrol against some Phytopathogenic Fungi: Treatment of Tomato Seeds. J. Basic. Appl. Sci. Res 2014, 4, 1–9. [Google Scholar]
- Husain, A.; Hassan, Z.; Huda-Faujan, N.; Nizam Lani, M. Antifungal Activity of Lactic Acid Bacteria Isolated from Soil Rhizosphere on Fusarium Species Infected Chilli Seeds. Technol. Sci. Am. Sci. Res. J. Eng. 2017, 29, 182–202. [Google Scholar]
- Sathe, S.J.; Nawani, N.N.; Dhakephalkar, P.K.; Kapadnis, B.P. Antifungal lactic acid bacteria with potential to prolong shelf-life of fresh vegetables. J. Appl. Microbiol. 2007, 103, 2622–2628. [Google Scholar] [CrossRef]
- Lipińska, L.; Klewicki, R.; Klewicka, E.; Kołodziejczyk, K.; Sójka, M.; Nowak, A. Antifungal activity of lactobacillus sp. Bacteria in the presence of xylitol and galactosyl-xylitol. BioMed Res. Int. 2016, 2016, 5897486. [Google Scholar] [CrossRef] [Green Version]
- Cavanagh, D.; Fitzgerald, G.F.; McAuliffe, O. From field to fermentation: The origins of Lactococcus lactis and its domestication to the dairy environment. Food Microbiol. 2015, 47, 45–61. [Google Scholar] [CrossRef] [PubMed]
- Schnürer, J.; Magnusson, J. Antifungal lactic acid bacteria as biopreservatives. Trends Food Sci. Technol. 2005, 16, 70–78. [Google Scholar] [CrossRef]
- Cortés-Zavaleta, O.; López-Malo, A.; Hernández-Mendoza, A.; García, H.S. Antifungal activity of lactobacilli and its relationship with 3-phenyllactic acid production. Int. J. Food Microbiol. 2014, 173, 30–35. [Google Scholar] [CrossRef]
- Khalaf, E.M.; Raizada, M.N. Bacterial seed endophytes of domesticated cucurbits antagonize fungal and oomycete pathogens including powdery mildew. Front. Microbiol. 2018, 9, 42. [Google Scholar] [CrossRef] [PubMed]
- Zebboudj, N.; Yezli, W.; Hamini-kadar, N.; Mebrouk, K. Antifungal activity of lactic acid bacteria against Fusarium oxysporum f. sp. albedinis isolated from diseased date palm in south Algeria. Int. J. Biosci. 2014, 5, 99–106. [Google Scholar] [CrossRef]
- Dalié, D.K.D.; Deschamps, A.M.; Richard-Forget, F. Lactic acid bacteria—Potential for control of mould growth and mycotoxins: A review. Food Control 2010, 21, 370–380. [Google Scholar] [CrossRef]
- Šušković, J.; Kos, B.; Beganović, J.; Pavunc, A.L.; Habjanič, K.; Matoć, S. Antimicrobial activity—The most important property of probiotic and starter lactic acid bacteria. Food Technol. Biotechnol. 2010, 48, 296–307. [Google Scholar]
- Batish, V.K.; Roy, U.; Lal, R.; Grower, S. Antifungal Attributes of Lactic Acid Bacteria—A Review. Crit. Rev. Biotechnol. 1997, 17, 209–225. [Google Scholar] [CrossRef]
- Le Lay, C.; Coton, E.; Le Blay, G.; Chobert, J.-M.; Haertlé, T.; Choiset, Y.; Van Long, N.N.; Meslet-Cladière, L.; Mounier, J. Identification and quantification of antifungal compounds produced by lactic acid bacteria and propionibacteria. Int. J. Food Microbiol. 2016, 239, 79–85. [Google Scholar] [CrossRef]
- Sjögren, J.; Magnusson, J.; Broberg, A.; Schnürer, J.; Kenne, L. Antifungal 3-Hydroxy Fatty Acids from Lactobacillus plantarum MiLAB14. Appl. Environ. Microbiol. 2003, 69, 7554–7557. [Google Scholar] [CrossRef] [Green Version]
- Zhou, F.; Zhao, H.; Bai, F.; Piotr, D.; Liu, Y.; Zhang, B. Purification and characterisation of the bacteriocin produced by Lactobacillus plantarum, isolated from Chinese pickle. Czech J. Food Sci. 2014, 32, 430–436. [Google Scholar] [CrossRef] [Green Version]
- Rocha-Mendoza, D.; Kosmerl, E.; Krentz, A.; Zhang, L.; Badiger, S.; Miyagusuku-Cruzado, G.; Mayta-Apaza, A.; Giusti, M.; Jiménez-Flores, R.; García-Cano, I. Invited review: Acid whey trends and health benefits. J. Dairy Sci. 2021, 104, 1262–1275. [Google Scholar] [CrossRef]
- Rama, G.R.; Kuhn, D.; Beux, S.; Maciel, M.J.; Volken de Souza, C.F. Potential applications of dairy whey for the production of lactic acid bacteria cultures. Int. Dairy J. 2019, 98, 25–37. [Google Scholar] [CrossRef]
- Catone, M.V.; Palomino, M.M.; Legisa, D.M.; Fina Martin, J.; Monedero García, V.; Ruzal, S.M.; Allievi, M.C. Lactic acid production using cheese whey based medium in a stirred tank reactor by a ccpA mutant of Lacticaseibacillus casei. World J. Microbiol. Biotechnol. 2021, 37, 1–13. [Google Scholar] [CrossRef]
- De Simone, N.; Capozzi, V.; de Chiara, M.L.V.; Amodio, M.L.; Brahimi, S.; Colelli, G.; Drider, D.; Spano, G.; Russo, P. Screening of Lactic Acid Bacteria for the Bio-Control of Botrytis cinerea and the Potential of Lactiplantibacillus plantarum for Eco-Friendly Preservation of Fresh-Cut Kiwifruit. Microorganisms 2021, 9, 773. [Google Scholar] [CrossRef] [PubMed]
- Canpolat, E.; Doğaner, M.M.; Derviş, S.; Ulubaş Serçe, Ç. Antifungal Activity of Some Lactic Acid Bacteria Against Several Soil-borne Fungal Pathogens Isolated from Strawberry Plants. Turkish J. Agric. Food Sci. Technol. 2018, 6, 1163. [Google Scholar] [CrossRef]
- Murthy, K.N.; Malini, M.; Savitha, J.; Srinivas, C. Lactic acid bacteria (LAB) as plant growth promoting bacteria (PGPB) for the control of wilt of tomato caused by Ralstonia solanacearum. Pest Manag. Hortic. Ecosyst. 2012, 18, 60–65. [Google Scholar]
- Suproniene, S.; Semaskiene, R.; Juodeikiene, G.; Mankeviciene, A.; Cizeikiene, D.; Vidmantiene, D.; Basinskiene, L.; Sakalauskas, S. Seed treatment with lactic acid bacteria against seed-borne pathogens of spring wheat. Biocontrol Sci. Technol. 2015, 25, 144–154. [Google Scholar] [CrossRef]
- El-Mabrok, A.S.W.; Hassan, Z.; Mokhtar, A.M.; Hussin, K.M.A. Antifungal activity of Lactobacillus plantarum LAB-C5 and LAB-G7 isolated from Malaysian fruits. Acta Biol. Malaysiana 2013, 2, 22–30. [Google Scholar] [CrossRef]
- Daranas, N.; Roselló, G.; Cabrefiga, J.; Donati, I.; Francés, J.; Badosa, E.; Spinelli, F.; Montesinos, E.; Bonaterra, A. Biological control of bacterial plant diseases with Lactobacillus plantarum strains selected for their broad-spectrum activity. Ann. Appl. Biol. 2019, 174, 92–105. [Google Scholar] [CrossRef] [Green Version]
- Magnusson, J.; Ström, K.; Roos, S.; Sjögren, J.; Schnürer, J. Broad and complex antifungal activity among environmental isolates of lactic acid bacteria. FEMS Microbiol. Lett. 2003, 219, 129–135. [Google Scholar] [CrossRef] [Green Version]

| Strain | Origin |
|---|---|
| Alternaria alternata ŁOCK 408 | Collection of Pure Cultures of Industrial Microorganisms ŁOCK at the Lodz University of Technology (Łódź, Poland) |
| Alternaria tenuissima DSM 63360 | German Collection of Microorganisms and Cell Cultures GmbH (DSMZ, Braunschweig, Germany) |
| Fusarium sambucinum DSM 62397 | |
| Rhizoctonia solani DSM 22843 | |
| Colletotrichum coccodes DSM 62126 | |
| Phoma exigua DSM 62040 | |
| Streptomyces scabiei DSM 4077 | |
| Fusarium oxysporum Z154 | Plant Breeding and Acclimatization Institute (IHAR)—National Research Institute (Radzików, Poland) |
| Alternaria solani Z184 | |
| Pectobacterium carotovorum PCM 2056 | Polish Collection of Microorganisms of the Hirszfeld Institute of Immunology and Experimental Therapy of the Polish Academy of Sciences (Wrocław, Poland) |
| LAB Species | Number of Active LAB Species against Potato Phytopathogens | |||||||||
|---|---|---|---|---|---|---|---|---|---|---|
| Fusarium oxysporum | Fusarium sambucinum | Alternaria alternata | Alternaria solani | Alternaria tenuissima | Colletotrichum coccodes | Rhizoctonia solani | Phoma exigua | Pectobacterium carotovorum | Streptomyces scabiei | |
| Lactococcus lactis [N = 9] | 0 | 0 | 0 | 0 | 0 | 0 | 0 | 0 | 7 | 4 |
| Leuconostoc mesenteroides [N = 9] | 1 | 1 | 1 | 2 | 1 | 3 | 1 | 1 | 9 | 6 |
| Lacticaseibacilllus casei [N = 2] | 1 | 1 | 0 | 0 | 0 | 2 | 1 | 0 | 2 | 2 |
| Lactobacillus acidophilus [N = 19] | 17 | 17 | 7 | 19 | 17 | 19 | 17 | 13 | 19 | 19 |
| Lactiplantibacillus plantarum [N = 47] | 41 | 42 | 15 | 45 | 44 | 44 | 35 | 31 | 44 | 33 |
| Levilactobacillus brevis [N = 4] | 4 | 4 | 1 | 4 | 4 | 4 | 3 | 3 | 4 | 3 |
| Lacticaseibacillus paracasei [N = 2] | 2 | 1 | 0 | 2 | 2 | 2 | 2 | 0 | 2 | 2 |
| Lactiplantibacillus pentosus [N = 1] | 1 | 1 | 1 | 1 | 1 | 1 | 1 | 1 | 1 | 1 |
| Lactobacillus farraginis [N = 1] | 1 | 1 | 1 | 1 | 1 | 1 | 0 | 1 | 1 | 0 |
| Lactobacillus sp. [N = 6] | 5 | 6 | 4 | 6 | 6 | 6 | 2 | 5 | 6 | 2 |
| Analytical Analysis | Medium | ||
|---|---|---|---|
| A100 M100 Acid Whey-Based Medium | Acid Whey without Supplementation | MRS (Based on Distilled Water) | |
| Phosphorus [mg/L] | 185.02 | 182.41 | 192.20 |
| Nitrogen [mg/L] | 183.65 | 38.71 | 190.24 |
| Iron [mg/L] | 11.00 | 6.50 | 10.00 |
| Potassium [mg/L] | 101.80 | 74.50 | 97.90 |
| Calcium [mg/L] | 461.00 | 325.00 | 2.50 |
| Chloride [mg/L] | 18.70 | 57.30 | 0.56 |
| Sodium [mg/L] | 30.10 | 62.30 | 5.20 |
| Lactose [g/L] | 10.00 | 15.00 | 0.30 |
| Lactic acid [g/L] | 15.96 | 15.95 | 1.20 |
| Protein [g/kg] | 27.21 | 8.66 | 22.84 |
| Total solids [g/kg] | 104.78 | 58.72 | 53.05 |
| Volatile solids [g/kg] | 83.48 | 48.16 | 45.07 |
| Water content [g/kg] | 895.22 | 941.28 | 946.95 |
| Phytopathogens | Inhibition of Potato Infestation [%] | |
|---|---|---|
| A100 M100 Acid Whey-Based Medium | MRS Medium | |
| Fusarium oxysporum | - | - |
| Fusarium sambucinum | - | - |
| Alternaria alternata | 60 ± 10 | 60 ± 5 |
| Alternaria solani | 75 ± 10 * | 10 ± 5 * |
| Alternaria tenuissima | 50 ± 5 * | 25 ± 5 * |
| Colletotrichum coccodes | 75 ± 5 * | 50 ± 10 * |
| Rhizoctonia solani | 40 ± 5 | 40 ± 5 |
| Phoma exigua | 70 ± 0 * | 100 ± 0 * |
| Pectobacterium carotovorum | 90 ± 10 | 85 ± 5 |
| Streptomyces scabiei | 85 ± 0 * | 75 ± 5 * |
Publisher’s Note: MDPI stays neutral with regard to jurisdictional claims in published maps and institutional affiliations. |
© 2022 by the authors. Licensee MDPI, Basel, Switzerland. This article is an open access article distributed under the terms and conditions of the Creative Commons Attribution (CC BY) license (https://creativecommons.org/licenses/by/4.0/).
Share and Cite
Steglińska, A.; Kołtuniak, A.; Motyl, I.; Berłowska, J.; Czyżowska, A.; Cieciura-Włoch, W.; Okrasa, M.; Kręgiel, D.; Gutarowska, B. Lactic Acid Bacteria as Biocontrol Agents against Potato (Solanum tuberosum L.) Pathogens. Appl. Sci. 2022, 12, 7763. https://doi.org/10.3390/app12157763
Steglińska A, Kołtuniak A, Motyl I, Berłowska J, Czyżowska A, Cieciura-Włoch W, Okrasa M, Kręgiel D, Gutarowska B. Lactic Acid Bacteria as Biocontrol Agents against Potato (Solanum tuberosum L.) Pathogens. Applied Sciences. 2022; 12(15):7763. https://doi.org/10.3390/app12157763
Chicago/Turabian StyleSteglińska, Aleksandra, Artur Kołtuniak, Ilona Motyl, Joanna Berłowska, Agata Czyżowska, Weronika Cieciura-Włoch, Małgorzata Okrasa, Dorota Kręgiel, and Beata Gutarowska. 2022. "Lactic Acid Bacteria as Biocontrol Agents against Potato (Solanum tuberosum L.) Pathogens" Applied Sciences 12, no. 15: 7763. https://doi.org/10.3390/app12157763
APA StyleSteglińska, A., Kołtuniak, A., Motyl, I., Berłowska, J., Czyżowska, A., Cieciura-Włoch, W., Okrasa, M., Kręgiel, D., & Gutarowska, B. (2022). Lactic Acid Bacteria as Biocontrol Agents against Potato (Solanum tuberosum L.) Pathogens. Applied Sciences, 12(15), 7763. https://doi.org/10.3390/app12157763

